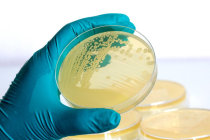

Cientistas dos Estados Unidos modificam molécula da vancomicina aumentando sua atividade contra superbactérias
Acredita-se que uma versão modificada do antibiótico vancomicina seja muito mais eficaz na luta contra a bactéria1 Enterococci, que é encontrada em hospitais e pode causar graves infecções2. A droga, que tem sido usada há 60 anos, é descrita como um antibiótico de último recurso, usada apenas após falha do tratamento com outros antibióticos. Mas algumas infecções2 tornaram-se resistentes mesmo à vancomicina na sua forma atual.
A equipe de pesquisa do The Scripps Research Institute em San Diego, Califórnia, descreveu a nova droga como "mágica" em sua força, já que a vancomicina passa a ser uma ameaça tripla para infecções2 resistentes, agindo de três formas diferentes e dificultando a resistência das bactérias ao antibiótico. No entanto, pode levar anos até a conclusão dos ensaios clínicos3 necessários para transformar a descoberta de laboratório em um medicamento produzido em massa.
O estudo, publicado na revista Proceedings of the National Academy of Sciences, diz que a modificação na estrutura da molécula da vancomicina, aumentando sua potência antimicrobiana e sua durabilidade, aumenta em 1000 vezes a sua atividade para combater uma infecção4.
"Os microrganismos simplesmente não podem trabalhar simultaneamente para encontrar um meio de enfrentar três mecanismos de ação independentes", disse Dale Boger, que liderou a pesquisa e é co-presidente do departamento de química do The Scripps Research Institute. "Mesmo que eles encontrem uma solução para um desses mecanismos, ainda seriam mortos pelos outros dois".
Embora promissora, a droga reestruturada não é eficaz contra todos os tipos de bactérias resistentes e não vai curar a resistência aos antibióticos. Esta vem aumentando para níveis perigosamente elevados em todo o mundo, ameaçando a capacidade de tratar infecções2 comuns, como pneumonia5, tuberculose6, gonorreia7 e septicemia8, adverte a Organização Mundial da Saúde9.
Veja mais sobre "Pneumonia5", "Tuberculose6", "Gonorreia7", "Infecção4 hospitalar" e "Septicemia8".
Fonte: PNAS, publicação online em 30 de maio de 2017